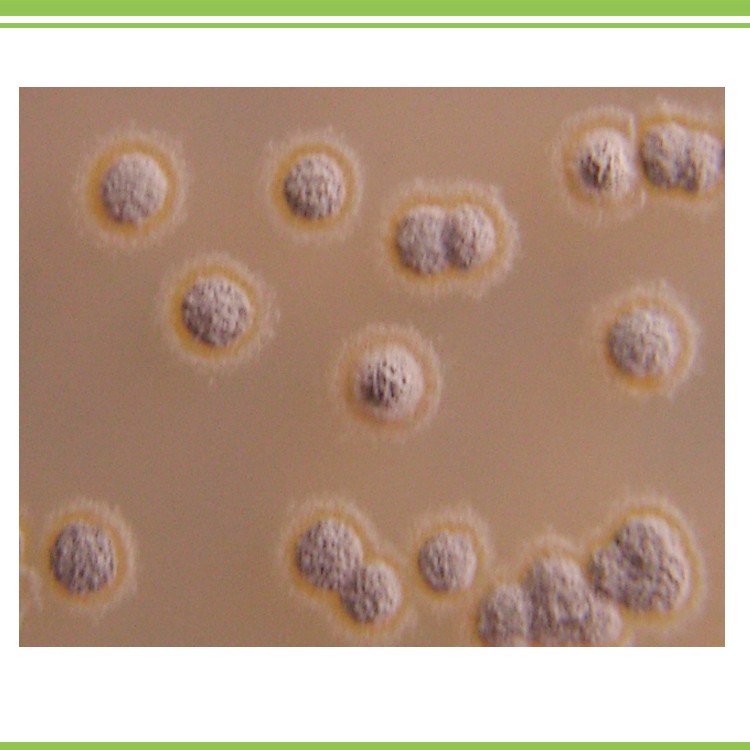

Порошок микробные большие дезодоранты для ферментирования/эффективный
- Категории: Microecology >>>
- Поставщик: Hebei,New,Century,Zhoutian,Biotechology,Co.,Ltd.,[Hebei,China]Hebei
Поделиться:
Описание и отзывы
Характеристики

Животноводческая ферма ферментационная подстилка биомикроорганизмы инокулянт
Описание:
Животноводческая ферма ферментационная подстилка биомикроорганизмов инокулянт, изготовленный из высокотехнологичной биологической технологии фермента, основной используется для повышения температуры домашнего скота, эффективного разложения отходов животного, уменьшения содержания аммиака скота, способствует здоровью и росту скота, увеличивает доход животноводов.
Особенности:
1.По технологии биоферментации, инокулянт может эффективно увеличить температуру ферментационная подстилка, обеспечить комфортные условия роста для скота, уменьшить Болезни поросят от холодных и влажных условий.
2.Биомикроорганизмы, инокулянты содержат количество полезных микроорганизмов, которые могут разлагать выброс животных и другие отходы, уменьшить запах аммиака (дезодорирование), уменьшить количество комаров, вредных бактерий, повысить здоровье скота.
3.К ферментационная подстилка ферменту и терзанию температурного процесса, инокулянт может эффективно убить вредные бактерии в ферментационная подстилка году, увеличить полезное количество микроорганизмов. Эти полезные микроорганизмы могут улучшить микрофлору животноводства, увеличить использование корма, повысить рост скота, повысить качество скота.
4.Биомикроорганизм инокулянт может уменьшить потребление воды животноводческой фермы, уменьшить стоимость, лом ферментационная подстилка также может быть использован в качестве органического удобрения.
Спецификация:
Эффективный жизнеспособным микроорганизма штук (колониеобразующих единиц) ≥0. 2 млрд/g
Применение:
Смешайте инокулянт с соломой, пилой пылью, арахисовым скорлупой, пшеничными или рисовыми отрубями по тарифу 1:1000.
Посылка:
1 кг на алюминиевую сумку
Примечание:
- 1.Подальше от детей.
- 2.Не использовать средство вместе с бактерицидом.
- 3.Должны храниться под герметичным, транспортироваться и хранить в прохладном и нормальном состоянииТемпература (5-35 ℃)ИзбегайтеЗащита от солнцаСвет.
Полка времени:Два года.





























